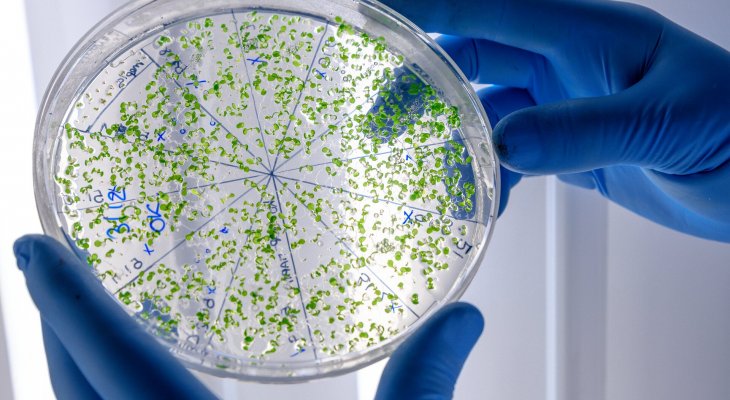
A koronavírus eredete

Egy COVID-nyomozó jelentése Kínából
A koronavírus (COVID-19, vagy SARS-CoV-2) már több, mint egy éve foglalkoztatja az egész világot. Ebben az elmúlt, rögös időszakban temérdek kérdés fogalmazódott meg az emberekben a járványról: Honnan indult? Mi okozta? Kik a felelősek ezért az egészért? Ezekre a kérdésekre az Egészségügyi Világszervezet (WHO) is igyekezett minél előbb választ találni, ezért egy szakértői csoportot küldött Kínába, hogy feltárják a vírus eredetét.
Az egyik ilyen szakértő Dominic Dwyer volt, aki kutatótársaival együtt utazott Kínába. Dominic nyilvános összefoglalója később a The Guardian online kiadásában jelent meg – ennek a cikknek magyar fordítását olvashatod az alábbiakban:
Részt vettem a WHO kínai Covid-missziójában, és ezekre jutottunk
Nem, nem egy Wuhani piacról származik, de meglehet, hogy fagyasztott élelmiszereken keresztül terjedt el. Ezeket derítettük ki a vizsgálat első szakaszában.
Miközben ezeket a sorokat írom, épp egy szállodai karanténban ülök Sydneyben, miután visszatértünk Vuhanból, Kínából. Én voltam az ausztrál képviselő abban a vizsgálatban, amelyet az Egészségügyi Világszervezet (WHO) indított a SARS-CoV-2 vírus eredetének ügyében.
A COVID-19 vírus eredetét vizsgáló missziót számos politikai hozzászólás övezi. Könnyen megfeledkezünk arról, hogy az ilyen vizsgálatok mögött valódi emberek állnak.
A misszió részeként találkoztunk azzal a férfival, akit 2019 december 8-án az első COVID-19-es esetként azonosítottak; azóta már felépült. Találkoztunk annak az orvosnak a férjével, aki belehalt a COVID-19-be, és hátrahagyott egy fiatal gyermeket. Találkoztunk azokkal az orvosokkal, akik a vuhani kórházakban dolgoztak és kezelték az első COVID-19-es eseteket, illetve megtudtuk, hogy mi történt velük és a munkatársaikkal. Szemtanúi voltunk annak is, hogy milyen hatása volt a COVID-19-nek azokra a személyekre és közösségekre, amelyeket korábban érintett a járvány, amikor még nem tudtunk sokat vírusról, hogy hogyan terjed, hogyan kezelhető a COVID-19, vagy, hogy milyen hatásai lehetnek.
Beszéltünk a kínai hasonmásainkkal is – tudósokkal, epidemiológusokkal, orvosokkal – az alatt a négy hét alatt, amit Kínában töltöttünk a WHO misszió keretei között. Napi 15 órás megbeszéléseket tartottunk velük, amelyek során nem csak munkatársak lettünk, hanem össze is barátkoztunk velük. Ez lehetővé tette, hogy olyan tiszteletet és bizalmat építsünk ki egymás iránt, amit nem feltétlenül lettünk volna képesek Zoom vagy emailek segítségével.